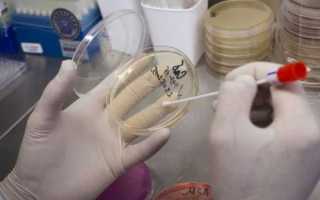
Гемотест урологический мазок на флору

Содержание
Зачем нужен гинекологический мазок на флору и где его сдать: Инвитро и другие лаборатории
Мазок на флору — это методика обследования, предполагающая, что врач берет небольшое количество материала со слизистой, который исследуется на предмет наличия бактерий и микроорганизмов, являющихся возбудителями заболеваний мужских и женских половых органов. Такое название он носит, поскольку с его помощью врач может оценить состояние микрофлоры половой системы.
Мазок на флору — основной анализ, с помощью которого оценивается состояние микрофлоры мочеполовой системы
Исследование выполняется по назначению гинеколога или уролога (у мужчин). Показаниями к нему являются следующие факторы:
- жжение в области половых органов;
- зуд;
- боли и дискомфортные ощущения внизу живота;
- выделения;
- кровотечение;
- планирование беременности.
У женщины мазок берется в гинекологическом кресле специальным шпателем, которым материал для исследования наносится на стекло. В урологии применяется зонд, с помощью которого делается соскоб из уретры. Глубина его введения – не более трех сантиметров, поскольку именно на этом участке скапливаются бактерии.
Для того чтобы подготовиться к исследованию, рекомендуется:
- за 24 часа воздержаться от половых контактов;
- не употреблять накануне сдачи алкоголь;
- не принимать ванну;
- не пользоваться свечами и влагалищными таблетками;
- за два часа не мочиться.
Сдать гинекологический и урологический мазок можно как в специализированной клинике, так и в лаборатории, при условии, что в ней оборудован кабинет гинеколога.
Планируя исследование во время беременности, стоит уточнить в выбранной лаборатории, делает ли она такой анализ. Многие из них берут мазок только до определенного срока – как правило, до 18-20 недель.
- Лаборатории Инвитро. Стоимость анализа составляет 550 руб., взятие материала – 400 р.
- Гемотест. Цена исследования – 440 р., взятие материала – 400 р.
- ЦИР. Исследование стоит 430 руб. (без учета забора). Цена экспресс-анализа (от одного часа) – 860 р. Цены будут ниже, если оформлять оплату через Интернет.
- Поколение NEXT. Цена без забора материала – 260 р., для мужчин – 150 рублей. Есть возможность взять материал из одной точки (уретра, влагалище или шейка) за 150 р.
- Он-Клиник. Стоимость с учетом забора составляет 650 рублей.
- Кроме того, сдать анализ бесплатно можно в любой женской консультации: он входит в разряд базовых, которые делаются, в том числе, и в государственных районных медицинских учреждениях.
На результаты мазка могут влиять многие факторы – например, беременность у женщин, прием антибиотиков и другие. Кроме того, методика обработки, используемое оборудование и критерии оценки могут отличаться в разных лабораториях, поэтому подробной расшифровкой анализа должен заниматься врач.
до 30до 5Превышение нормального уровня свидетельствует о воспалении
отклонений
беременности – до 20)
Нередко значения на бланке обозначаются не словами, а знаками « »
- — в незначительном количестве;
- — умеренно;
- — количество увеличено;
- — обильно.
Сегодня брала мазок на флору в гемотесте, и вот при вытаскивании зеркала Медсестра умудрилась меня прищемить. Ужас! Это больно и до сих пор жутко неприятно, жалко себя((( но я задумалась: а это не опасно? У кого-нибудь вообще такое бывало или я одна такая?
На втором скрининге узистка сказала что утолщена немного плацента, надо бы провериться на инфекции. Сдала вчера обычный мазок на флору в жк и мазок на инфекции методом пцр в гемотесте. Результат из гемотеста не совсем сама разобрала, отправила подруге гинекологу. Она мне сказала что все в норме,чуть повышен Candida albicans,то бишь грибок вызывающий молочницу.